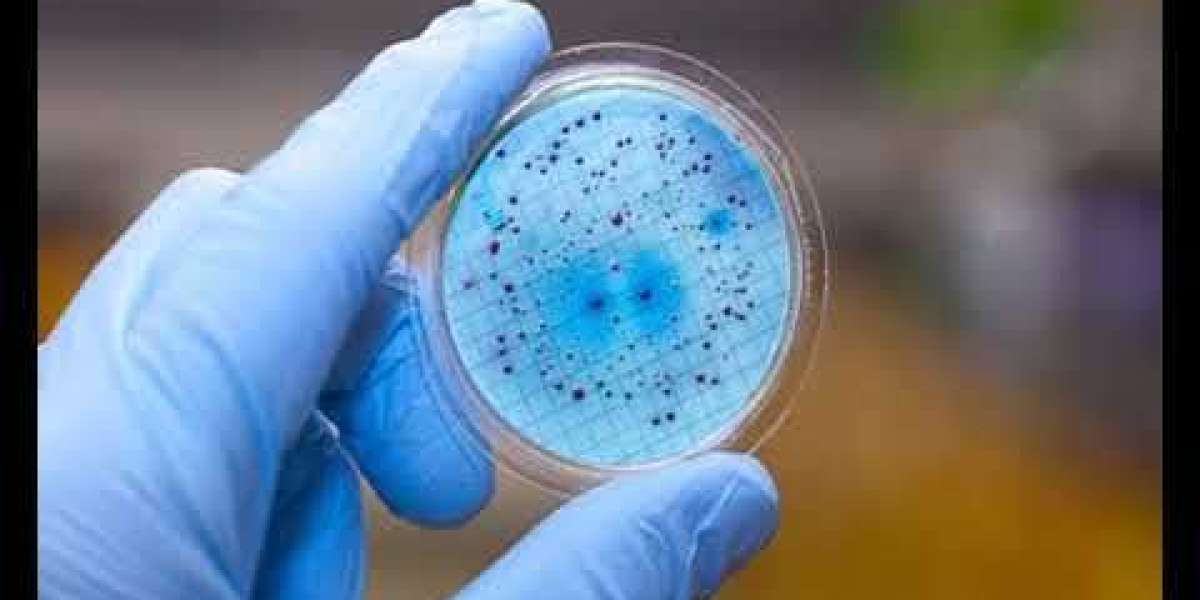

Залы переполнены, беговые дорожки в парках редко пустуют, а домашние тренировки через онлайн-программы выбирают даже те, кто раньше никогда не занимался спортом. При этом физическая активность всегда связана с дополнительными нагрузками на организм, и восполнить потребности только обычным питанием бывает непросто. Именно поэтому спортивные добавки прочно вошли в повседневность украинских спортсменов и любителей фитнеса.
Что такое спортивные добавки и зачем они нужны
Спортивные добавки — это продукты, разработанные для улучшения восстановления, повышения работоспособности и восполнения дефицита питательных веществ. Их задача — дополнить рацион, а не заменить обычную еду.
Для жителей Украины это особенно актуально, так как ритм жизни в крупных городах не всегда позволяет питаться строго по часам и готовить сбалансированные блюда каждый день. Добавки решают эту проблему — один коктейль или капсула могут закрыть часть потребностей организма без лишних хлопот.
Протеин — основа спортивного рациона
Протеин занимает первое место по популярности среди украинцев. Это концентрированный источник белка, необходимого для роста и восстановления мышц.
Сывороточный протеин быстро усваивается и подходит после тренировки.
Казеиновый протеин медленно усваивается и даёт долгосрочное чувство сытости, идеально для приёма перед сном.
Растительный протеин выбирают вегетарианцы и люди с непереносимостью лактозы.
Протеиновые коктейли удобны для перекусов и как дополнение к основным приёмам пищи. Это универсальная добавка, которая подойдёт как новичку, так и опытному спортсмену.
Гейнеры — помощь в наборе массы
Для тех, кто с трудом набирает вес, гейнеры становятся настоящим спасением. Это смесь белков и углеводов с добавлением витаминов и минералов. Они обеспечивают организм дополнительными калориями и энергией, что особенно важно при интенсивных тренировках или быстром обмене веществ.
Многие украинские спортсмены используют гейнеры в период активного набора массы или при подготовке к соревнованиям.

Аминокислоты и BCAA
BCAA (лейцин, изолейцин и валин) — одни из самых востребованных аминокислот в Украине. Их ценят за способность снижать усталость, защищать мышцы от разрушения и ускорять восстановление.
Аминокислотные комплексы выпускаются в виде капсул, порошков и готовых напитков. Их часто принимают до, во время и после тренировок, чтобы повысить выносливость и сократить время восстановления.
Креатин — энергия для силы и роста
Креатин — добавка, которая помогает мышцам быстрее воспроизводить энергию. Благодаря этому спортсмен может выполнять больше повторений, увеличивать вес на штанге и прогрессировать в тренировках.
Украинские атлеты активно используют креатин в силовых видах спорта, кроссфите и даже игровых дисциплинах, где требуется резкая вспышка энергии.
Жиросжигатели и L-карнитин
Для тех, кто стремится похудеть или «просушить» тело, важную роль играют жиросжигатели. Они ускоряют обмен веществ и помогают организму активнее использовать жировые запасы как источник энергии.
Особое место занимает L-карнитин, который безопасен и подходит даже новичкам. Он не только помогает сжигать жир, но и поддерживает работу сердца.
Витамины и минералы
Даже при сбалансированном рационе спортсмены теряют много полезных веществ вместе с потом. Поэтому витаминно-минеральные комплексы остаются одними из самых востребованных добавок.
Витамины группы B, витамин D, магний, цинк и кальций особенно важны для украинцев, так как их нехватка часто сказывается на работоспособности, иммунитете и здоровье суставов.
Изотоники и энергетические напитки
Во время длительных тренировок организм теряет много жидкости и электролитов. Изотоники восполняют этот дефицит, предотвращают обезвоживание и поддерживают оптимальный уровень энергии.
Энергетические напитки на основе аминокислот, кофеина и витаминов помогают повысить концентрацию и зарядиться энергией на весь тренировочный процесс.
Предтренировочные комплексы

Эта категория добавок особенно популярна среди тех, кто занимается интенсивными тренировками вечером после работы. Предтренировочные комплексы содержат комбинацию кофеина, креатина, аминокислот и витаминов, которые помогают «включиться» в тренировку, повысить концентрацию и силу.
Важно помнить, что их стоит принимать дозированно и не слишком поздно, чтобы не вызвать бессонницу.
Хондропротекторы и коллаген
С возрастом или при больших нагрузках суставы и связки нуждаются в дополнительной поддержке. Хондропротекторы и добавки с коллагеном помогают укрепить соединительные ткани, снизить риск травм и улучшить подвижность.
В Украине эти продукты особенно востребованы среди бегунов, любителей тяжёлой атлетики и людей старше 35 лет, которые хотят сохранить здоровье суставов.
Как избежать ошибок при выборе
Многие новички в Украине совершают одинаковые ошибки:
покупают слишком много разных добавок сразу;
ориентируются только на рекламу;
выбирают сомнительные бренды без сертификатов.
Чтобы спортпит приносил пользу, а не вред, нужно учитывать цели, уровень подготовки и индивидуальные особенности организма.
Где можно выгодно приобрести спортпит
Украинский рынок спортивного питания огромен, и важно выбирать проверенные площадки. Если вы хотите качественный спортпит купить без риска, обратите внимание на mega-mass.ua/ Этот интернет-магазин спортивного питания предлагает широкий ассортимент добавок: от базовых протеинов до специализированных комплексов для суставов и энергии. Доставка по всей Украине делает покупки удобными для жителей любых регионов — от Киева и Львова до небольших городов.
Спортивные добавки как часть образа жизни
Сегодня спортивные добавки в Украине — это не только выбор профессионалов. Их используют студенты, офисные работники, родители, которые находят время для фитнеса, и даже люди старшего возраста. Они стали частью культуры активного образа жизни.
Грамотно подобранный спортпит помогает быстрее достигать целей, улучшать самочувствие и получать удовольствие от тренировочного процесса. А надёжные магазины, такие как mega-mass.ua, делают качественные продукты доступными каждому.
Украинцы всё чаще осознают, что спортивные добавки — это не «чудо-средство», а инструмент для поддержки здоровья и прогресса. И именно от правильного выбора зависит, насколько эффективно они будут работать.